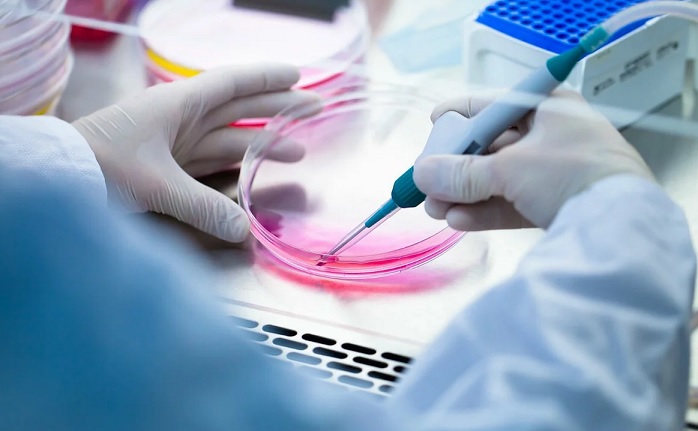
Gli scienziati superano il diabete con le cellule staminali in due settimane

foto da fonti aperte
foto da fonti aperte
Gli scienziati dell’Università di Washington trovano un nuovo modo la conversione delle cellule staminali umane nella produzione di insulina cellule, che aiuteranno a superare forme di diabete per sempre complesse. su Questo è riportato da Science Alert.
I ricercatori hanno identificato un modo per forzare le cellule pluripotenti, capace di trasformarsi in qualsiasi tessuto corporeo, trasformarsi nelle cellule beta del pancreas che producono insulina. Quando le cellule modificate sono state trapiantate in topi gravemente diabete, le condizioni degli animali sono migliorate rapidamente. Per due settimane, il livello di glucosio nel sangue dei roditori è tornato alla normalità ed è rimasto basso per molti mesi.
Il nuovo metodo riduce il numero di cellule laterali di altri tipi formati da cellule pluripotenti. Insieme a le cellule beta formano spesso altre cellule pancreatiche e il fegato, che non sono dannosi, ma non svolgono alcun ruolo controllo del glucosio e limitare l’effetto terapeutico dello stelo le cellule.
I risultati del lavoro aiuteranno a sviluppare un trattamento efficace. diabete in futuro se gli esperimenti vengono riprodotti con successo coinvolgere le persone.
fonte






